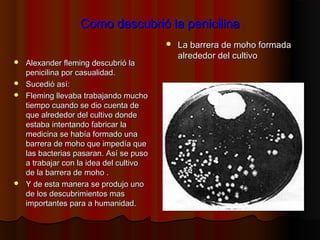
Como descubrió la penicilinaComo descubrió la penicilina
 Alexander fleming descubrió laAlexander fleming descubrió la
penicilina por casualidad.penicilina por casualidad.
 Sucedió así:Sucedió así:
 Fleming llevaba trabajando muchoFleming llevaba trabajando mucho
tiempo cuando se dio cuenta detiempo cuando se dio cuenta de
que alrededor del cultivo dondeque alrededor del cultivo donde
estaba intentando fabricar laestaba intentando fabricar la
medicina se había formado unamedicina se había formado una
barrera de moho que impedía quebarrera de moho que impedía que
las bacterias pasaran. Así se pusolas bacterias pasaran. Así se puso
a trabajar con la idea del cultivoa trabajar con la idea del cultivo
de la barrera de moho .de la barrera de moho .
 Y de esta manera se produjo unoY de esta manera se produjo uno
de los descubrimientos masde los descubrimientos mas
importantes para a humanidad.importantes para a humanidad.
 La barrera de moho formadaLa barrera de moho formada
alrededor del cultivoalrededor del cultivo

Alexander Fleming nació en 1881 en Escocia y murió en 1955 en Londres. Descubrió la penicilina de forma accidental al observar que un moho inhibía el crecimiento de las bacterias en uno de sus cultivos. La penicilina fue el primer antibiótico efectivo y salvó muchas vidas. Fleming dedicó su vida a la investigación bacteriológica y recibió el Premio Nobel de Medicina en 1945 por el descubrimiento de la penicilina.